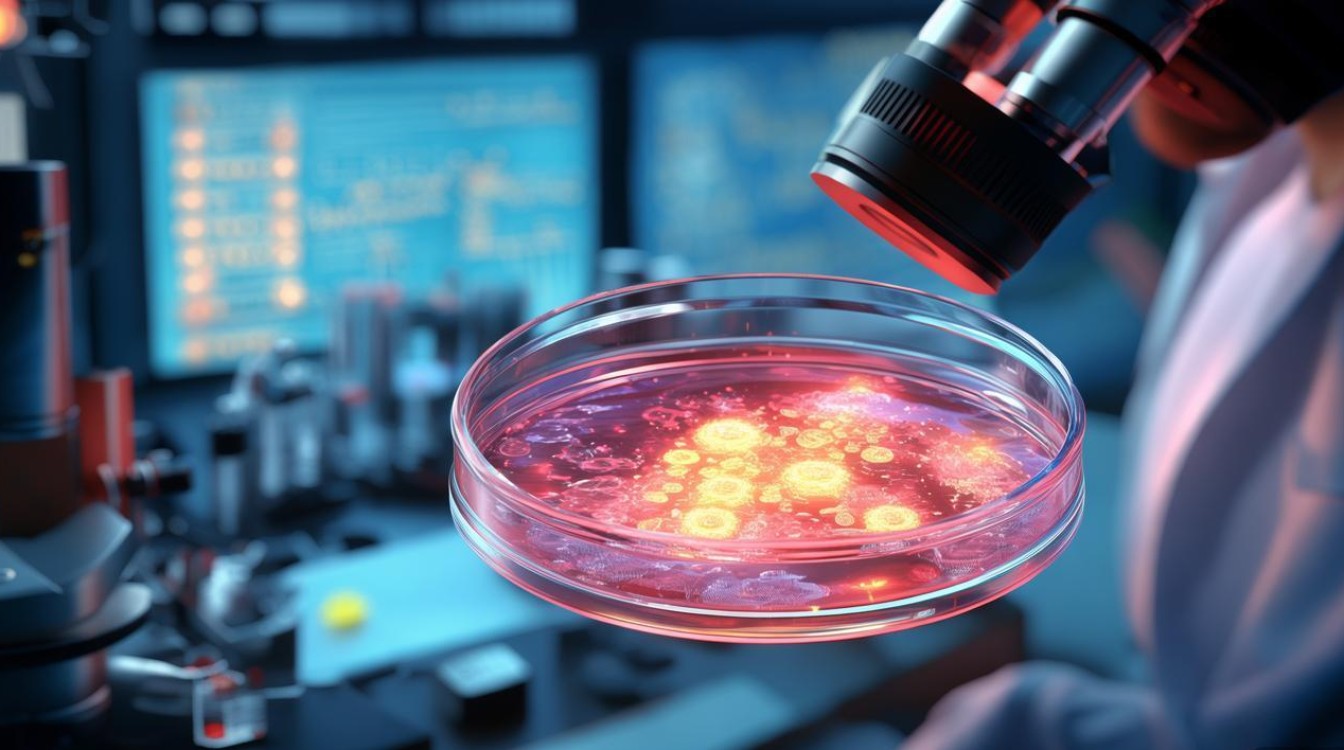
干细胞技术究竟是什么? 干细胞技术究竟是什么?

干细胞技术是现代生物医学领域最具突破性的前沿技术之一,它利用干细胞的自我更新和多向分化潜能,通过体外培养、诱导分化、基因编辑等手段,实现对受损组织或器官的修复、替代以及对疾病模型的构建和药物研发的革新,这一技术的核心基础在于干细胞独特的生物学特性:干细胞具有强大的自我更新能力,能够通过分裂产生与自身相同的子代细胞,维持干细胞池的稳定;它们具备多向分化的潜能,在特定条件下可以分化为多种类型的成熟细胞,如神经细胞、心肌细胞、胰岛细胞等,从而参与组织和器官的再生与修复。

根据发育阶段和分化潜能的不同,干细胞主要分为三类:胚胎干细胞、成体干细胞和诱导多能干细胞,胚胎干细胞来源于早期胚胎的内细胞团,具有全能性,理论上可以分化为机体所有类型的细胞,包括胎盘组织,但因其涉及伦理问题且存在致瘤风险,其研究和应用受到严格限制,成体干细胞存在于成年个体的各种组织中,如骨髓、脂肪、脐带、胎盘等,包括造血干细胞、间充质干细胞等,它们通常具有组织特异性,分化潜能相对有限,主要参与组织的更新和修复,且免疫原性较低,伦理争议较小,诱导多能干细胞则通过基因重编程技术,将体细胞(如皮肤细胞、血液细胞)诱导为多能干细胞,其特性与胚胎干细胞相似,但避开了胚胎干细胞的伦理问题,同时为患者提供了个性化的细胞来源,极大推动了再生医学的发展。
干细胞技术的应用领域广泛且潜力巨大,在再生医学方面,它为治疗传统医学难以攻克的重大疾病提供了新思路,通过将干细胞诱导为神经细胞,有望修复脊髓损伤、治疗帕金森病和阿尔茨海默病等神经系统疾病;将其分化为心肌细胞,可用于修复心肌梗死后的心脏损伤;而胰岛细胞的分化则可能为糖尿病患者提供替代治疗的细胞来源,已有部分干细胞疗法进入临床应用阶段,如造血干细胞移植治疗白血病和淋巴瘤已成为成熟的治疗手段,间充质干细胞在移植物抗宿主病和自身免疫性疾病的治疗中也显示出良好效果。
在疾病建模和药物研发领域,干细胞技术同样发挥着不可替代的作用,利用患者来源的诱导多能干细胞,可以构建疾病特异性细胞模型,模拟疾病的发生发展过程,为深入研究疾病机制提供理想的体外研究平台,通过这些细胞模型,研究人员能够高通量筛选药物、评估药物疗效和毒性,大幅缩短药物研发周期,降低研发成本,利用阿尔茨海默病患者来源的神经元细胞,科学家可以筛选出能够延缓疾病进程的候选药物,并在细胞层面验证其安全性。
干细胞技术在基础研究中也具有重要意义,通过对干细胞分化机制的研究,可以揭示细胞命运决定的分子调控网络,深化对个体发育、衰老和再生过程的理解,基因编辑技术(如CRISPR-Cas9)与干细胞技术的结合,为遗传性疾病的治疗开辟了新途径——通过修复患者干细胞中的致病基因,再将修复后的细胞移植回体内,有望实现根治遗传性疾病的目标。

干细胞技术的发展仍面临诸多挑战,首先是技术瓶颈,如干细胞定向分化的效率有待提高,分化后的细胞功能是否完全成熟、能否长期稳定存活等问题尚未完全解决,其次是安全性问题,干细胞移植可能存在致瘤风险(如未分化的干细胞残留导致畸胎瘤形成)、免疫排斥反应以及细胞移植后的异常分化等风险,伦理问题也是制约胚胎干细胞研究的重要因素,各国对此均有严格的法律法规进行规范,干细胞治疗的标准化和规范化问题亟待解决,包括干细胞的分离、培养、鉴定、储存等环节的质量控制,以及临床试验的设计和评估标准等。
尽管如此,随着技术的不断进步,干细胞技术在医学领域的应用前景依然广阔,随着基因编辑技术的完善、干细胞培养体系的优化以及临床研究的深入,干细胞疗法有望在更多疾病的治疗中实现突破,为人类健康事业做出更大贡献,结合3D生物打印技术,构建具有复杂结构和功能的组织和器官,为器官移植提供新的来源;利用干细胞外泌体等无细胞治疗产品,降低治疗风险并提高安全性等。
相关问答FAQs:
-
问:干细胞治疗和传统药物治疗有何本质区别?
答:传统药物治疗主要通过化学或生物分子作用于机体靶点,调节病理过程或缓解症状,多为“对症治疗”;而干细胞治疗则通过移植或激活干细胞,利用其分化、再生和免疫调节能力,修复受损组织、恢复器官功能,属于“对因治疗”和“再生治疗”,传统药物通常是小分子或大分子化合物,而干细胞治疗涉及活细胞,作用机制更复杂,且具有潜在的组织修复和再生能力,适用于传统药物难以治疗的组织损伤和退行性疾病。
-
问:目前干细胞治疗已经广泛应用于临床了吗?有哪些需要注意的风险?
答:目前并非所有干细胞疗法都广泛应用于临床,仅部分成熟技术(如造血干细胞移植)已成为标准治疗手段,而多数干细胞疗法仍处于临床试验阶段或临床前研究,潜在风险包括:致瘤风险(未分化的干细胞异常增殖)、免疫排斥(异体干细胞移植)、感染风险(细胞制备过程中污染)、疗效不确定性(部分疗法效果不明确)以及不规范治疗带来的健康危害(如某些机构未经批准的“干细胞美容”导致并发症等),患者在接受干细胞治疗时应选择正规医疗机构,确保治疗符合国家法规和临床规范。
- 上一篇:贺州事业单位招聘何时开始报名?
- 下一篇:m面是什么意思?
相关推荐
- 11-12 常州好厂有哪些?待遇发展怎么样?
- 11-12 军队文职考试具体考哪些科目与内容?
- 11-12 旅游定制师是做什么的?为何要选定制游?
- 11-12 硬件工程师具体是做什么的?
- 11-12 含章何意?
- 11-12 副总裁算高管吗?职责权限有哪些?
- 11-12 面试名单何时公布?
- 11-12 房地产销售的核心职责与关键能力是什么?
- 11-12 招聘会到底是什么?
- 11-12 人事专员具体负责哪些核心工作?
- 本月热门
- 最新答案
-
-

根据您所关心的内容,以下是关于深圳佳兆业物业的详细回答:工作氛围方面呈现积极向上态势,团队协作紧密且沟通顺畅;晋升体系对新员工友好开放透明化程度高有利于长期发展...
雨伞 回答于11-12
-

针对您所关心的问题,以下是从互联网获取的非广告性质的在职或前员工真实反馈:回复内容如下:【清远佳的美公司情况】以下是仿照BOSS直聘回答方式为您详细解答,...
风逸 回答于11-12
-

在BOSS直聘上查看企业的公示信息,您可以进入企业主页后找到公司介绍或类似名称的板块,在该板块中通常会有工商注册信息的链接或者相关描述以及经营状态的展示等基本信...
红尘醉人夜 回答于11-12
-

在BOSS直聘上查看企业的公示信息,您可以按照以下步骤操作:首先进入企业主页,在企业名称下方找到并点击工商认证或类似标识的按钮;页面跳转至详细的企业资质展示页后...
飞鸟游 回答于11-12
-

在BOSS直聘上查看企业的公示信息,可进入企业主页的公司介绍或相关标签页查找,这里会展示工商注册基本信息、经营状况等内容;若需更详尽的信息如经营异常状态等行政处...
王洁 回答于11-12
-

取消评论你是访客,请填写下个人信息吧